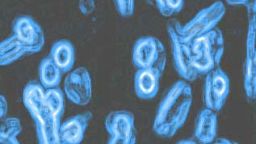

The Bomber Mafia nearly changed the world—and you've likely never heard of them.

Join Radiolab's Latif Nasser at 1pm ET today as he chats with Malcolm Gladwell live on Big Think.

As Malcolm Gladwell – author of numerous New York Times bestselling books – points out, mastery and popularity are sometimes linked, but often they are not. If your goal is to become masterful at what you do, the formula is really quite simple: stay focused and do your time. This is the theory behind the 10,000 Hours Rule that Gladwell made famous. Worrying about whether you’re being recognized for your efforts, i.e. popularity, is a product of the ego, not to mention a distraction. . . . So get over yourself and get to work! In this lesson, Gladwell teaches you how.

Embracing messiness and understanding that it is a contribution to the creative process is something that writers and creative types have got to cultivate.

Malcolm Gladwell: It drives me crazy when people in the technological sphere inflate the importance of the kind of tinkering they do with these sort of software gadgets that they come up with.

Malcolm Gladwell: I don’t know why we run from explanations of success that include a healthy dose of serendipity.

We always fall back on this notion that the rest of the world is somehow the way that we are.

"Do I want to spend time with this idea or this person?

Choking is honorable failure and panicking is dishonorable failure. It’s important to maintain a line between those two things.

Connecting the dots between hair care and the American belief in reinvention, Polykoff invented one of the most famous advertising taglines in history: “Does she or doesn’t she? Only her […]

Growing up in a war-torn country and contracting a very rare type of cancer, Nassim Taleb became fixed on the idea that catastrophe is more common than most people think—an […]

An inventor from the Jersey Boardwalk, Popeil’s great genius was to make the whole world care about something that previously only weirdly obsessed aficionados of kitchen gadget had cared about.

Can we make a better engine? Yes. Is the state of search technology the reason we haven’t found a cure for cancer? No.

Embracing intellectual messiness goes against our instincts and training as educated people, but writers and artists should accept and understand it as crucial to the creative process.

When you look beneath the surface of the everyday, you realize how radically different and unexpected other people’s experiences are from your own.

What the world craves is differentiation—the things that other people could never have imagined on their own.

A conversation with the author.